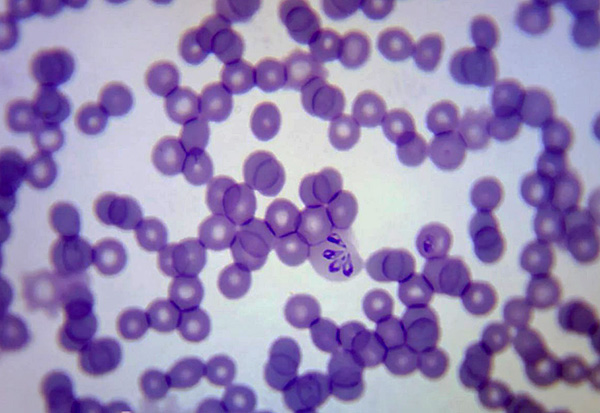

Il est important que le propriétaire d'un chien qui a été mordu par une tique (ou qui est régulièrement mordu par des tiques) surveille attentivement et puisse reconnaître à temps les symptômes des maladies qu'un animal peut infecter à cause d'un parasite. Une piqûre de tique pour un chien peut en effet être très dangereuse, et entraîner dans certains cas de graves conséquences pour l'animal.
Certaines infections transmises par les tiques se développent si rapidement que littéralement les heures comptent à partir du moment où les premiers symptômes apparaissent : si le propriétaire parvient à amener l'animal chez le vétérinaire pendant cette période, la vie du chien peut être sauvée. Cela ne fonctionnera pas - hélas...

Sur une note
Par conséquent, en passant, il est totalement irresponsable de compter sur le traitement d'un chien à la maison après l'apparition de symptômes évidents d'une infection par les tiques. Ces maladies ne sont pas traitées à domicile et leur traitement n'est possible qu'avec l'utilisation de moyens spécialisés. C'est le seul moyen d'éviter des conséquences graves pour l'animal.
La situation est encore compliquée par le fait qu'un chien peut être infecté par une maladie dangereuse lorsqu'il est mordu par une tique n'importe où: dans un parc de la ville, sur une pelouse dans la cour d'une maison privée, dans un champ de chasse, dans une forêt. Ici, même la région dans laquelle la morsure s'est produite ne joue aucun rôle : les infections transmises par les tiques les plus dangereuses sont omniprésentes et n'ont pas une focalisation géographique telle que, par exemple, l'encéphalite à tiques chez l'homme.
Dans le même temps, le parasite lui-même passe souvent inaperçu, en particulier chez les animaux à poils longs et épais. Et cela signifie que vous devez être bien conscient des signes de maladies qui se développent après les piqûres de tiques et y répondre correctement même lorsque le parasite lui-même ne semble pas avoir été retiré de l'animal (il peut boire du sang et tomber inaperçu).
Voyons quelles maladies un chien peut contracter d'une tique, quels symptômes signalent le développement des pathologies correspondantes et ce que le propriétaire de l'animal peut faire exactement en cas de maladie ...
Quelles maladies peuvent menacer un chien avec une morsure de tique
L'infection par les tiques la plus courante et la plus dangereuse pour les chiens est peut-être la piroplasmose. Elle est causée par la babésia, un protozoaire parasite du sang, c'est pourquoi on l'appelle aussi babésiose. Elle est mortelle pour les chiens de tous âges, mais les chiots et les jeunes animaux sont les plus gravement et le plus souvent mortels.

Selon le rythme de développement des symptômes et la nature de l'évolution, la piroplasmose est classée en plusieurs formes : chronique, aiguë et hyperaiguë.
Le premier conduit à un affaiblissement à long terme de la santé du chien, parfois au développement de conséquences irréversibles de la maladie, et à une réduction de l'espérance de vie. La forme aiguë de la piroplasmose sans traitement (ou avec un traitement inapproprié) se termine généralement par la mort de l'animal 5 à 7 jours après l'apparition des premiers symptômes, mais avec le traitement approprié, elle peut être guérie sans conséquences.
La forme hyperaiguë se manifeste généralement par la mort du chien sans développement de symptômes préliminaires, et ce n'est qu'à l'autopsie post-mortem que l'on trouve des piroplasmes dans le sang de l'animal.
Sur une note
Sous une forme suraiguë, la piroplasmose survient rarement chez le chien domestique. Plus souvent, cette forme se retrouve chez les renards.
La piroplasmose ne cesse d'étendre son aire de répartition et est aujourd'hui diagnostiquée dans toute l'Eurasie et l'Amérique du Nord. Si jusqu'en 1970-1980, il s'agissait principalement d'une maladie "professionnelle" des chiens de chasse, qui en étaient infectés par des tiques dans des biotopes naturels, au cours des dernières décennies, la piroplasmose a pénétré activement avec les tiques dans les villes. Aujourd'hui, les chiens en sont souvent infectés dans les cours, les parcs et les places.

C'est intéressant
La piroplasmose est une maladie "canine" typique. Ses principaux porteurs sont précisément les chiens domestiques, mais à l'état sauvage d'autres canidés en tombent également malades : renards, loups, chacals, chiens viverrins. Les chats atteints de piroplasmose sont extrêmement rares. Les bovins sont très sensibles à la piroplasmose, mais il n'y a toujours pas de consensus parmi les scientifiques sur la question de savoir si le même agent pathogène provoque la maladie chez les chiens et les bovins, ou si les espèces de Babesia qui se spécialisent dans différents hôtes diffèrent. Les gens ne contractent pas la piroplasmose.
Une autre maladie commune transmise par les tiques chez les chiens est la borréliose de Lyme. Il touche aussi les personnes, y compris, mais il est impossible de l'attraper directement d'un chien malade : l'agent pathogène ne peut être transmis que tique de la borréliose.
Avec la borréliose, presque tous les tissus du corps peuvent être affectés - du cerveau aux articulations, par conséquent, sous forme chronique ou aiguë, la borréliose peut se manifester par une grande variété de symptômes. La maladie est mortelle pour les chiens, mais relativement facile à traiter avec un diagnostic rapide et une sélection appropriée des médicaments.

Parmi les autres infections transmises par les tiques qui sont dangereuses pour les chiens, il convient de souligner les suivantes :
- La fièvre pourprée est une maladie aussi dangereuse pour l'homme que pour l'animal.Elle est rare en Eurasie, plus typique du continent nord-américain (elle est aussi appelée fièvre pourprée des montagnes Rocheuses). Représente un danger épidémiologique insignifiant du fait que la transmission de l'agent pathogène ne se produit que quelques heures après la succion de la tique. Habituellement, avant cela, ils ont déjà le temps de le détecter et de le supprimer. Les décès d'animaux et d'humains dus à la fièvre boutonneuse sont rares et surviennent en l'absence de diagnostic et de traitement, ou lorsque la maladie est détectée trop tard.
- L'hépatozoonose est une maladie causée par le protozoaire Hepatozoon canis et transmise principalement en mangeant des tiques. En raison de l'absence de symptômes spécifiques, l'hépatozoonose est souvent confondue avec d'autres maladies, ce qui retarde le traitement approprié. La maladie entraîne relativement rarement la mort, les conséquences graves de l'infection se développent généralement soit avec un affaiblissement brutal de l'immunité de l'animal, soit avec le développement simultané d'une autre maladie;
- Ehrlichiose granulocytaire, connue principalement aux États-Unis. En dehors du continent nord-américain, des cas ont été signalés dans les pays nordiques. Il est également dangereux pour les chiens, et pour les personnes, et pour le bétail (chevaux, vaches, chèvres). Cependant, les décès dus à l'ehrlichiose ne sont pas connus chez les chiens ou les humains;
- La bartonellose est une maladie spécifique des chats, relativement rarement transmise aux chiens et capable d'entraîner la mort d'un animal sous sa forme négligée. La maladie est courante sous les tropiques ; en Eurasie, seuls des cas isolés ont été signalés.
Sur une note
Mais les chiens ne contractent pas l'encéphalite à tiques.Néanmoins, la piroplasmose est à peu près aussi dangereuse pour eux que l'encéphalite pour l'homme, et les agents responsables de ces maladies sont véhiculés par des tiques de la même espèce (à quelques exceptions près).
Sur la photo ci-dessous - tique du chien (Ixodes ricinus), le vecteur le plus courant d'encéphalite à tiques et de piroplasmose en Europe et dans la partie européenne de la Russie :
En raison de l'intersection partielle des zones d'infections transmises par les tiques (par exemple, la piroplasmose et la borréliose se produisent dans les mêmes régions), il est souvent difficile de comprendre de quelle maladie spécifique souffre un chien. L'incertitude est aggravée par le fait que les premiers symptômes des infections transmises par les tiques sont souvent similaires.
Premiers symptômes à surveiller
Toutes les maladies du chien causées par des infections transmises par les tiques, à la fin de la période d'incubation, se manifestent par des symptômes généraux non spécifiques. Ceux-ci inclus:
- Température corporelle élevée chez l'animal - supérieure à 40 ° C (à raison de 39 ° C), nez sec, signes évidents de fièvre;
- Léthargie, réticence de l'animal à bouger, à marcher;
- Démarche chancelante et instable ;
- Respiration lourde, essoufflement.
Pour la piroplasmose, le dernier symptôme - respiration lourde - est plus pertinent que pour d'autres maladies. Le fait est qu'avec cette maladie, les globules rouges qui transportent l'oxygène sont détruits. Les tissus du corps de l'animal commencent à subir une hypoxie, le chien doit respirer plus souvent et plus profondément afin d'obtenir plus d'oxygène à chaque respiration.
Cependant, avec le développement de la fièvre dans d'autres maladies, la respiration de l'animal devient également plus profonde et plus lourde que d'habitude.
Sur une note
Il est intéressant de noter que les chiens avec une résistance accrue du système immunitaire, ou ceux qui ont déjà eu la piroplasmose, la tolèrent sous une forme plus douce avec un complexe de symptômes différent. Ils peuvent ne pas avoir de fièvre, mais seulement perdre l'appétit et devenir moins actifs.

Souvent, mais pas toujours, d'autres symptômes peuvent se développer avec la piproplasmose :
- Faiblesse évidente des pattes postérieures - le chien s'accroupit dessus, essayant de marcher;
- Diarrhée avec caillots sanguins ;
- Vomissements, également avec du sang ;
- Muqueuses pâles de la cavité buccale.
Un trait caractéristique de la piroplasmose est la couleur foncée de l'urine (on l'appelle aussi la couleur des "slops de viande" - marron, semblable à la couleur du thé fort). Cependant, il n'apparaît pas immédiatement après la fin de la période d'incubation, mais le 2-3ème jour de la maladie, lorsque le chien est généralement amené chez le vétérinaire et qu'il parvient à diagnostiquer la maladie.
Avec la borréliose chez le chien, comme chez l'homme, il existe un érythème migrant annulaire - rougeur en forme d'anneau autour du site de la morsure, augmentant progressivement de taille et "s'étendant" sur les côtés.

La fièvre pourprée et l'hépatozoonose présentent rarement des symptômes spécifiques qui ne se retrouvent pas dans d'autres maladies. Avec eux, l'état du chien s'aggrave tout simplement, il devient léthargique, sa température augmente et son appétit disparaît. En fait, c'est précisément à cause de cette similitude des symptômes que le diagnostic d'urgence des maladies est difficile, et pour un diagnostic précis, au moins un test sanguin périphérique est nécessaire.
Par la tique elle-même ou par l'apparition de la piqûre, il est impossible de déterminer si le chien s'est infecté (à l'exception de l'apparition d'un érythème migrant sur la peau, au cours de l'évolution duquel on peut d'abord parler de borréliose).

Cela ne peut pas être fait à l'aide d'analyses effectuées dans les premiers jours, avant la destruction massive des tissus et cellules cibles par l'agent pathogène. Tout ce qui est demandé au propriétaire est de surveiller attentivement l'état de l'animal et de prêter attention à tout changement dans son comportement.
Certains vétérinaires recommandent de prendre la température de votre chien tous les jours après une piqûre de tique pendant la période d'incubation. D'autres pensent que cette mesure est redondante, car lorsque la température augmente, le comportement de l'animal change en conséquence (et de manière assez sensible).
Période d'incubation des infections transmises par les tiques chez le chien
Pour les principales infections à tiques auxquelles les chiens sont sensibles, les premiers symptômes apparaissent en moyenne 1 à 2 semaines après l'infection. Avec la piroplasmose, la période d'incubation dure généralement 10-18 jours, avec l'ehrlichiose - 8-12, avec l'hépatozoonose - 10-14.
Parallèlement, la durée de la période d'incubation dépend du nombre d'agents infectieux transmis au chien par une morsure, du poids de l'animal lui-même et de l'état physique général, y compris l'état du système immunitaire.
Sur une note
Par exemple, la période d'incubation de la piroplasmose chez les petits chiens domestiques de races décoratives - Pékinois, Yorkshire terriers, teckels nains - peut durer 4 à 5 jours, et chez les grands chiens de berger, les premiers signes de la maladie peuvent apparaître même 20 jours après la morsure.
Dans tous les cas, les symptômes d'une infection par les tiques ne se développent pas immédiatement. La morsure d'une tique ne provoque pas immédiatement une détérioration de l'état de l'animal en soi. Si, par exemple, un chien mordu a vomi une heure ou deux après la découverte du parasite, dans la plupart des cas, cela n'est pas lié à la morsure elle-même.
Vous devez également tenir compte du fait qu'une tique infectée peut mordre un animal de compagnie sans que le propriétaire ne s'en aperçoive. Ainsi, les petites nymphes sont à peine perceptibles dans la laine épaisse des mêmes Yorkies, Pékinois et, plus encore, des chiens de berger du Caucase ou des Labradors. Et pour toute particularité de comportement, il est presque impossible de comprendre que le chien a attrapé une tique - le parasite mord sans douleur et ne dérange pas sa victime. Par conséquent, après une morsure, le chien peut commencer à développer une maladie qui sera une surprise totale pour le propriétaire - il n'a pas vu de tique et ne s'attend pas à ce que l'animal puisse être infecté.
Par exemple, la photo ci-dessous montre une petite nymphe de tique, qui ne serait pas si facile à remarquer dans une laine épaisse, mais qui peut aussi être porteuse d'infections :

Cela signifie qu'en saison des tiques (en Russie, au Kazakhstan et dans les pays européens - d'avril à octobre), vous devez surveiller attentivement l'état des animaux domestiques et agir immédiatement dès l'apparition des premiers symptômes d'une infection par les tiques. Cela dépend parfois de la rapidité et de la précision avec laquelle le propriétaire du chien réagit aux signes de la maladie, que l'animal survive ou non.
Premiers soins pour un animal de compagnie
Si une tique est trouvée sur un chien, elle doit être retirée dès que possible effacer. Les agents responsables des maladies sont transmis à l'animal précisément avec la salive du parasite, et la tique la sécrète par portions avec de longues pauses - jusqu'à plusieurs heures entre les actes de succion du sang. Plus le parasite est éliminé rapidement, moins il injectera de salive dans la plaie et moins il y aura de risque d'infection.
Encore une fois, faisons attention aux priorités : la rapidité d'élimination des tiques est plus importante que l'exactitude et la technicité de ce processus.Il vaut mieux arracher la tique avec les doigts immédiatement après la détection que de ramener le chien à la maison pendant une demi-heure, de fabriquer un ticker à partir de moyens improvisés, puis de dévisser doucement la tique pendant encore dix minutes. Même s'il arrive que la trompe du parasite reste dans la plaie - ce n'est pas si important, elle peut être retirée plus tard, à son retour à la maison.
Sur une note
En toute justice, il convient de noter qu'avec une simple séparation d'une tique de la peau d'un chien, ses mâchoires restent extrêmement rares dans la plaie. Le type de tique le plus courant et le plus nombreux qui pique les canines en Europe et dans la partie européenne de la Russie - la tique du chien - ne forme pas d'étui de cimentation dans la plaie lorsqu'il est mordu, et donc son gnathosome est faiblement fixé dans la peau et lorsqu'il est détaché , il est facilement retiré de la plaie.
Si vous avez un spécial dissolvant de tiques, alors le parasite doit être soigneusement dévissé. S'il n'y a pas de dispositif, vous devriez essayer de dévisser la tique avec vos doigts (sans appuyer sur son corps). Vous pouvez tordre dans le sens des aiguilles d'une montre et dans le sens inverse des aiguilles d'une montre.
La photo ci-dessous montre clairement qu'un gros acarien suceur de sang peut être saisi avec des doigts avec des ongles suffisamment longs:

Après avoir détaché le parasite, il doit être soigneusement examiné: si les mâchoires dépassent de la tête sous la forme d'une petite aiguille, tout est en ordre et aucune partie du parasite ne reste dans la peau du chien. Si la tête de la tique n'est pas visible, cela signifie qu'elle est restée dans la plaie. Vous devez essayer de l'enlever avec une aiguille, une pince à ongles ou même un cure-dent de la même manière qu'une écharde ordinaire est enlevée.
Ensuite, il est utile d'examiner le chien et d'essayer de trouver d'autres tiques dessus. Si elle en a attrapé un, alors là où elle a couru, ces parasites vivent, et elle aurait pu en attraper quelques autres. Vous devez examiner particulièrement attentivement les oreilles, le cou, le museau, les aisselles, l'aine, les espaces entre les doigts. Si d'autres tiques sont trouvées, elles sont également supprimées.
En règle générale, le chien ne fait pas attention à la morsure. Parfois, l'animal commence à peigner la plaie à cause des démangeaisons (la bosse ici peut démanger). Dans ce cas, il est utile de traiter la trace d'une piqûre de tique avec une pommade anesthésique - Trauma-gel, Levomekol, Traumex, Iruksovetin, etc.
Si plus tard un abcès, une inflammation, un ulcère suintant ou une dermatite apparaît au site de la morsure, le chien doit être montré au vétérinaire.

En même temps, n'en faites pas trop et faites des actions inutiles. Cela n'a aucun sens d'emmener votre chien chez le vétérinaire pour un traitement immédiatement après une morsure de tique. De plus, vous n'avez pas besoin de porter une tique pour l'examen, car les laboratoires n'analysent pas le parasite pour la piroplasmose. Enfin, vous n'avez pas besoin de donner à titre prophylactique à votre animal de compagnie des médicaments contre la piroplasmose. Ces médicaments sont très toxiques, et à titre préventif sans signes de développement de la maladie, il est interdit de les utiliser.
Les mesures de premiers secours ci-dessus suffisent amplement. Après avoir retiré la tique, la nécessité d'une action supplémentaire ne se fait sentir que lorsque les symptômes de la maladie apparaissent. Dans le même temps, les démarches que le propriétaire de l'animal doit entreprendre sont relativement simples.
Que faire lorsque les symptômes de la maladie apparaissent?
Si pendant la saison d'activité des tiques, et plus encore pendant la période d'incubation standard après une piqûre de parasite, le chien présente des symptômes de la maladie, il doit être emmené chez le vétérinaire dès que possible.C'est le spécialiste de l'époque qui pourra diagnostiquer la maladie, choisir la tactique de traitement et l'arsenal des moyens nécessaires, puis effectuer la thérapie avec une efficacité maximale.

Si le voyage chez le vétérinaire nécessite plus de 5 heures de conduite, il vaut la peine d'appeler le médecin avant le voyage et de savoir ce qu'il est souhaitable de faire tout de suite. Pour certains symptômes, il est judicieux de donner au chien un traitement symptomatique afin d'atténuer un peu son état.
Sur une note
Dans des cas exceptionnels, une utilisation unique de médicaments contre la piroplasmose est autorisée s'il est impossible de se rendre chez le vétérinaire pour une raison ou une autre. Par exemple, des signes de maladie se développent chez un chien vivant dans une région éloignée, ou à ce moment, les circonstances ne permettent pas d'amener l'animal à la clinique. Dans ce cas, vous devez appeler le médecin par téléphone et obtenir de lui des instructions sur les médicaments et les quantités à administrer à l'animal. En règle générale, il s'agit de l'un des principaux médicaments anti-babesion - Berenil, Azidin, Veriben ou leurs analogues.
Il convient de noter que dans les zones où il n'y a pas de cliniques vétérinaires, il n'est généralement pas possible d'acheter rapidement de tels médicaments, vous devez donc veiller à leur disponibilité à l'avance.
Diagnostic et traitement de la piroplasmose en clinique
Dans le cas optimal, le chien, après l'apparition des symptômes de la piroplasmose, est emmené à la clinique, où le médecin prélève son sang pour analyse. Babesia se trouve dans le sang au microscope, sur la base duquel le médecin établit un diagnostic approprié.
Ci-dessous, sur une photographie prise au microscope, les babésies sont clairement visibles dans les cellules sanguines :
En règle générale, le sang est prélevé de l'oreille, car la présence de babésie est plus facilement déterminée dans le sang périphérique.L'analyse du sang veineux pour la piroplasmose n'est pas informative. La procédure de prise de sang est quelque peu douloureuse, mais dans la plupart des cas, les chiens la tolèrent calmement en raison de l'apathie générale et de la faiblesse.
Immédiatement après la détection de babésies dans le sang, le chien reçoit une injection d'un médicament étiotropique qui vous permet de détruire rapidement ces parasites particuliers. Tous les médicaments pour le traitement de la piroplasmose sont administrés en quantités correspondant au poids corporel de l'animal. Ils sont très toxiques, provoquent souvent des effets secondaires graves et leur surdosage est donc inacceptable. C'est en partie pourquoi ils sont hautement indésirables pour une utilisation par quiconque autre qu'un vétérinaire professionnel.
De plus, le médecin peut administrer au chien des moyens de traitement symptomatique - anti-inflammatoires, stimulants respiratoires, diurétiques (pour détoxifier le corps) et autres. Ils soulagent l'état de l'animal, soulagent les symptômes et accélèrent la récupération. Dans certains cas, les chiens gravement affaiblis reçoivent un goutte-à-goutte pour fournir au corps des nutriments.

Le traitement est effectué à la clinique jusqu'au début d'améliorations évidentes de l'état de l'animal. Lorsque l'état est normalisé, les propriétaires ramènent l'animal à la maison et utilisent les médicaments prescrits par le médecin jusqu'à la fin du traitement. Le vétérinaire recommande une nutrition pendant cette période de rééducation, en se concentrant sur les caractéristiques individuelles du chien.
Si le chien n'est pas traité, alors le 5-7ème jour de la maladie sous une forme aiguë, la température de l'animal descend en dessous de la normale physiologique, une paralysie des membres postérieurs se produit puis la mort. Dans la forme chronique, la piroplasmose peut se terminer par une guérison complète à différents moments - de 3 à 12 semaines.
Traitement d'autres maladies
D'autres infections transmises par les tiques sont également diagnostiquées avec un test sanguin.Il trouve soit des parasites spécifiques (par exemple, avec l'ehrlichiose), soit révèle des modifications de la composition du sang, caractéristiques de la même hépatozoonose ou fièvre boutonneuse.
La borréliose et l'ehrlichiose sont traitées avec des antibiotiques de la série des tétracyclines, et relativement simples et abordables - tétracycline ou doxycycline; la borréliose est également traitée avec succès avec de la pénicilline (amoxicilline, ampicilline) et des antibiotiques céphalosporines (ceftriaxone, céfotaxime).

Habituellement, dès le lendemain de la première injection du médicament, l'état du chien s'améliore sensiblement, la température revient à la normale et après 2-3 jours, l'animal récupère presque complètement.
L'hépatozoonose est plus difficile à traiter. On pense qu'aucun remède moderne ne permet d'éliminer complètement l'agent pathogène du corps. Dans une certaine mesure, les antibiotiques, qui sont utilisés en conjonction avec des médicaments anti-inflammatoires, permettent de soulager l'état de l'animal. Cependant, même avec un traitement correct, 2 à 3 mois après l'exacerbation initiale, une rechute peut survenir, nécessitant un traitement répété. En règle générale, un chien atteint d'hépatozoonose peut vivre jusqu'à un an avec un traitement approprié, mais il est difficile d'obtenir un rétablissement complet.
Comment réduire le risque d'infection de votre chien par une morsure de tique
Avec tout le danger et l'étendue de la distribution de la piroplasmose et de la borréliose, il n'existe aucun moyen de prévention spécifique de ces maladies. Les vaccinations contre la piroplasmose (par exemple, Pirostop, Pirodog) sont inefficaces, assez chères et quelque peu dangereuses pour les chiens, de sorte que l'opportunité de leur utilisation est réfutée par de nombreux vétérinaires, mais est principalement bien accueillie par les fabricants et les vendeurs des vaccins eux-mêmes.

Les mesures de prévention non spécifiques sont plus accessibles et plus sûres, mais n'offrent pas non plus une protection absolument fiable pour les animaux domestiques. Ces outils et méthodes comprennent :
- Gouttes sur le garrot des tiques et des puces. Les parasites ne mordent pas un chien correctement et en temps opportun traités avec de telles gouttes;
- Colliers et sprays répulsifs. Les premiers sont mis sur le cou des chiens, les seconds sont aspergés de leur pelage juste avant de sortir ;
- Examens approfondis du chien après avoir marché pendant la saison d'activité des tiques, peignage et élimination rapide des parasites trouvés ;
- Changer le lieu de promenade du chien après la détection de tiques dessus.
Diverses combinaisons et vêtements pour chiens ne protègent pratiquement pas contre les piqûres de tiques.
En conclusion, il convient de noter une fois de plus que pendant la période d'activité des tiques, le propriétaire du chien doit être très attentif à son état, même si, en fait, la tique sur l'animal n'a jamais été retrouvée. Avec la détection rapide des symptômes d'infections transmises par les tiques et la réponse appropriée à celles-ci, dans la plupart des cas, l'animal peut être complètement guéri et sans conséquences graves pour sa santé.
Si vous avez une expérience personnelle dans le traitement d'un chien après une morsure de tique, assurez-vous de partager l'information en laissant votre avis au bas de cette page.
Ce qu'il est important pour un propriétaire de chien de savoir sur la piroplasmose




